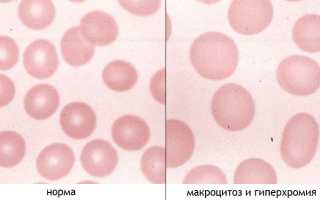

Гиперхромия → гиперхромная анемия
К моменту анализа мазка врач может уже заметить избыток гемоглобина в красных кровяных клетках и изменение их окраски по цветовому показателю (ЦП).
При гиперхромии цветовой показатель будет выше 1,1 — это предел для нормальных значений ( нормохромия: ЦП – 0,85 – 1,05). Эритроцитарные индексы (MCH, MCHC), рассчитанные с помощью гематологического анализатора, также будут важны.
Гиперхромия — основной лабораторный признак гиперхромных анемий, часто наблюдающийся в сочетании с макроцитозом (гиперхромная макроцитарная анемия). К таким состояниям относятся авитаминоз В12 и дефицит фолатов (фолиевой кислоты – витамина B9). Эти состояния являются типичными представителями гиперхромных макроцитарных (мегалобластных) анемий. Мегалобластные анемии характеризуются увеличением клеток, представленными мегалобластами и мегалоцитами, с диаметром более 10 мкм. Это значительно превышает размер макроцитов (7-8 мкм – нормоциты, более 8 мкм – макроциты, менее 7 мкм – микроциты). Таким образом, мегалобластная анемия подразумевает макроцитарную, но не каждая макроцитарная анемия является мегалобластной.
При морфологическом анализе образцов крови от пациентов с гиперхромной макроцитарной анемией можно выявить:
- Красные кровяные клетки, насыщенные гемоглобином, так что он полностью затмевает центральное просветление – гиперхромия (гиперхромазия);
- Диаметр эритроцитов превышает 10 мкм (макроциты и мегалоциты);
- Наблюдаются фрагменты красных кровяных телец (шизоцитоз), анизоцитоз (что подтверждается автоматической обработкой пробы с показателями: средний объем эритроцитов – MCV, ширина распределения по объему – RDW, гистограмма), а также изменение формы эритроцитов (пойкилоцитоз);
- Часто встречаются красные клетки с ядерными структурами (тельца Жолли, кольца Кебота, полихроматофильные элементы);
- Содержание молодых форм эритроцитов – ретикулоцитов в начале остается в пределах нормы, однако по мере прогрессирования заболевания наблюдается ухудшение дифференцировки и снижение их количества;
- Также следует обратить внимание на изменения в белой крови: снижение уровня лейкоцитов (нейтрофилов, моноцитов, эозинофилов), отсутствие базофилов и незначительное увеличение лимфоцитов. В некоторых случаях в кровь попадают молодые предшественники белых клеток – миелоциты и юные (сдвиг лейкоцитарной формулы влево);
- В тромбоцитарном звене могут наблюдаться аномалии (тромбоциты становятся гигантскими, но общее их количество снижено).
Вся эта картина (гиперхромия, макроцитоз и сдвиг лейкоцитарной формулы) обусловлена мегалобластическим типом кроветворения в костном мозге, что является общим признаком всех анемий подобного типа (связанных с нарушением синтеза ДНК). Эти анемии могут быть как наследственными, так и приобретенными в течение жизни.
Гиперхромия и гиперхромная анемия представляют собой состояния, связанные с изменениями в составе крови, которые могут указывать на различные заболевания. Врачи отмечают, что гиперхромия характеризуется повышенным содержанием гемоглобина в эритроцитах, что может быть следствием дефицита витаминов, таких как B12 и фолиевая кислота. В анализах крови наблюдаются увеличенные размеры эритроцитов и высокий уровень цветового показателя.
Течение гиперхромной анемии может быть разнообразным: от легкой формы, не требующей серьезного вмешательства, до тяжелых состояний, требующих госпитализации. Врачи подчеркивают важность своевременной диагностики и лечения, которое может включать витаминные препараты, коррекцию питания и, в некоторых случаях, трансфузии крови. Регулярный мониторинг анализов крови позволяет отслеживать динамику состояния пациента и корректировать терапию.

Все начинается в костном мозге
Гиперхромная макроцитарная анемия возникает из-за мегалобластического кроветворения. Рассмотрим анемию, связанную с дефицитом витамина В12:
- В костном мозге наблюдается высокая клеточная активность из-за большого количества ядерных элементов. Это приводит к мегалобластическому кроветворению и неэффективному образованию эритроцитов.
- Процесс деления клеток, которые должны стать полноценными эритроцитами, нарушается. Они значительно увеличиваются в размерах, превращаясь в мегалобласты, и изменяется их структура: ядро становится нежно-сетчатым, а созревание ядра и цитоплазмы происходит не одновременно.
- В группе созревающих мегалобластов, в зависимости от активности кроветворения в костном мозге, наблюдается значительная вариативность: некоторые клетки более зрелые, другие — менее. Если в костном мозге преобладают промиелобласты или базофильные клетки, специалисты говорят о «синем» костном мозге.
- Характерной особенностью крупных клеток является раннее насыщение их цитоплазмы хроматопротеином при неизменном нежном ядре. Это приводит к гемоглобинезации цитоплазмы и гиперхромии.
- В ядрах происходят заметные дегенеративные изменения (митозы, разрушение клеточного ядра), что делает их уродливыми и неполноценными. Такие клетки долго не живут, большинство из них не достигает зрелости и «умирает» на стадии «рождения».
- Из оставшихся предшественников эритроцитов формируются мегалоциты (их жизнь также коротка) и макроциты, которые становятся основным лабораторным признаком гиперхромной макроцитарной анемии.
- Нарушение клеточного деления влияет на синтез красного пигмента, что затрудняет образование красных кровяных клеток. Разрушение ядер и распад мегалобластов приводят к усиленному, но неэффективному эритропоэзу.
- Недостаток витамина В12 также вызывает изменения в белой крови. Предшественники зрелых лейкоцитов (промиелоциты, миелоциты, юные и палочкоядерные клетки), а также зрелые сегментоядерные лейкоциты меняют свои размеры. Иногда изменения касаются и тромбоцитов, что объясняет изменения в анализах крови у пациентов с гиперхромной макроцитарной анемией.
Изменения в периферической крови и костном мозге при фолиеводефицитной анемии аналогичны тем, что наблюдаются при дефиците витамина В12. Это связано с тем, что фолиевая кислота тесно взаимодействует с витамином В12 в процессе синтеза пуриновых оснований, необходимых для правильного формирования ДНК.
| Показатель | Гиперхромия | Гиперхромная анемия |
|---|---|---|
| Определение | Повышенное содержание гемоглобина в эритроцитах (среднее содержание гемоглобина в эритроците (МСН) > 36 пг, средняя концентрация гемоглобина в эритроците (МСНС) > 36%) | Анемия (сниженное количество эритроцитов или гемоглобина) с одновременным повышением содержания гемоглобина в отдельных эритроцитах. |
| Изменения в анализе крови | ↑ МСН, ↑ МСНС, нормальное или сниженное количество эритроцитов (RBC), может быть нормальный или сниженный уровень гемоглобина (Hb) и гематокрита (Ht) | ↓ Hb, ↓ Ht, ↓ RBC, ↑ МСН, ↑ МСНС |
| Причины гиперхромии | Мегалобластная анемия (дефицит витамина B12 или фолиевой кислоты), гемолитическая анемия (в некоторых случаях), алкоголизм, лечение некоторыми лекарственными препаратами. | Дефицит витамина B12 (пернициозная анемия), дефицит фолиевой кислоты, редко – наследственные нарушения синтеза ДНК. |
| Течение заболевания | Зависит от причины. Может быть бессимптомным или проявляться симптомами основного заболевания. | Утомляемость, слабость, одышка, тахикардия, бледность кожи и слизистых, глоссит (воспаление языка), мегалобластная анемия может вызывать неврологические симптомы. |
| Лечение | Лечение основного заболевания. При мегалобластной анемии – назначение витамина B12 или фолиевой кислоты. | Заместительная терапия витамином B12 или фолиевой кислотой (в зависимости от причины). Лечение сопутствующих заболеваний. Трансфузия крови в тяжелых случаях. |
Очень кратко о причинах и симптомах
Термин «анемия» не обозначает конкретное заболевание, а представляет собой клинический синдром, указывающий на хронический недостаток кислорода в организме. Анемия может привести к серьезным заболеваниям, таким как ишемическая болезнь сердца (ИБС) и сердечная недостаточность, которые нельзя игнорировать.
Важно обращать внимание на причины анемического синдрома. Рассмотрим состояния, связанные с лабораторным показателем гиперхромии:
- Авитаминоз В12 возникает из-за недостаточного поступления цианокобаламина с пищей, нарушений всасывания в кишечнике, конкуренции за усвоение с паразитами, а также проблем с поджелудочной железой, других заболеваний ЖКТ и воздействия токсинов. Некоторые случаи В12-дефицита могут быть наследственными.
- Фолиеводефицитная анемия чаще всего затрагивает вегетарианцев, пожилых людей, страдающих алкоголизмом, и женщин в период беременности.
- Мегалобластная анемия с гиперхромией возникает при нарушении работы ферментов, отвечающих за синтез пуриновых и пиримидиновых оснований, что нарушает синтез ДНК и РНК.
- Гиперхромия (и макроцитоз) может быть следствием серьезных заболеваний печени, которые нарушают усвоение витаминов. В печени накапливаются многие витамины, включая В12 и В9, участвующие в синтезе пуриновых и пиримидиновых оснований.
- Гиперхромия в красных кровяных клетках может наблюдаться при миелодиспластическом синдроме или некоторых формах гемолитических анемий, однако этот признак не является постоянным и зависит от стадии и формы заболевания.
Гиперхромия также может возникать из-за кислородного голодания, особенно у курильщиков. Организм курильщика, испытывающий постоянную гипоксию, может реагировать на неблагоприятные условия подобным образом. У курильщиков уровень гемоглобина в крови выше, чем у некурящих, что связано с эпизодической гиперхромией, а не с гиперхромной анемией.
Симптомы мегалобластных (макроцитарных) гиперхромных анемий включают:
- Общие симптомы, характерные для всех подобных состояний (слабость, головные боли, бледность, тахикардия);
- Специфические симптомы (жжение языка, неуверенная походка).
При В12-дефиците страдают кровь, желудочно-кишечный тракт и нервная система (триада синдромов), тогда как для фолиеводефицитного состояния изменения в нервной системе не характерны.
Чаще всего в медицине встречается комбинированный вариант: В12-фолиеводефицитная анемия. Симптомы, причины и диагностика этого состояния подробно описаны в соответствующей публикации (В12-дефицитная и фолиеводефицитная анемия).
Гиперхромия и гиперхромная анемия — это состояния, связанные с изменениями в крови, которые могут вызывать беспокойство у пациентов. Гиперхромия характеризуется повышенным содержанием гемоглобина в эритроцитах, что может указывать на различные заболевания, включая легочные и сердечно-сосудистые расстройства. В анализах крови это проявляется увеличением среднего содержания гемоглобина в эритроците (MCH) и цветового показателя.
Гиперхромная анемия, в свою очередь, связана с недостатком железа или витаминов, что приводит к образованию крупных и насыщенных гемоглобином эритроцитов. Симптомы могут включать усталость, слабость и бледность кожи. Лечение зависит от причины: может включать прием железосодержащих препаратов, витаминов или изменение диеты. Важно своевременно обратиться к врачу для диагностики и назначения адекватной терапии, чтобы избежать осложнений и улучшить качество жизни.

Как лечить гиперхромию?
Лечение гиперхромии как отдельного состояния не предусмотрено. Основное внимание уделяется терапии авитаминоза В12, фолиеводефицитного состояния или, чаще, В12-фолиеводефицитной анемии.
Терапия фолиеводефицитной анемии включает назначение препаратов витамина В9, известного как фолиевая кислота. Однако важно проявлять осторожность, если нет уверенности в диагнозе. Неправильное применение витамина В9 может привести к нежелательным последствиям. Заболевание, не связанное с дефицитом фолатов, не только не исчезнет, но и может проявиться более ярко. В таких случаях целесообразнее назначить цианокобаламин.
Лечение авитаминоза В12 основывается на трех ключевых принципах:
- Обеспечить организм достаточным количеством цианокобаламина.
- Постоянно восполнять запасы недостающего витамина.
- Предотвращать развитие анемии, так как с ней в дальнейшем будет сложно справиться.
Таким образом, это основные моменты, касающиеся лечения двух типов гиперхромных макроцитарных анемий (или их сочетанного варианта). Более детальную информацию можно найти на одной из страниц нашего сайта в публикации, упомянутой ранее (В12-дефицитная и фолиеводефицитная анемия).
В заключение, для эффективного лечения пациенту следует помнить о потребностях организма в витаминах и обогащать рацион продуктами, содержащими необходимые вещества.
Видео: о гиперхромных макроцитарных анемиях

Вопрос-ответ
Как лечить гиперхромную анемию?
Лечение гиперхромной анемии, вызванной дефицитом витамина В12, заключается также в правильном питании. Больному нужно есть мясо, рыбу, печень, сыр и другие продукты, содержащие витамин В12 и другие микроэлементы, необходимые для нормального функционирования организма.
Что означает гиперхромная анемия?
Гипохромная возникает, когда красные кровяные клетки становятся бледнее обычного (цветовой показатель менее 0,8). Железодефицитная анемия является примером гипохромной анемии. Иногда эритроциты при анемии становятся ярче обычного (цветовой показатель выше 1,05). В этом случае говорят о гиперхромной анемии.
К чему приводит гипохромная анемия?
При микроцитарной гипохромной анемии (ЖДА, железодефицитной) возникает недостаток железа. Он и приводит к сокращению числа эритроцитов. Дефицит железа могут провоцировать такие факторы, как нарушения его усвоения или поступления в организм.
Советы
СОВЕТ №1
Проводите регулярные анализы крови. Это поможет вам отслеживать уровень гемоглобина и других важных показателей, что особенно важно для раннего выявления гиперхромии и гиперхромной анемии.
СОВЕТ №2
Обратите внимание на свое питание. Убедитесь, что ваш рацион богат железом, витаминами B12 и фолиевой кислотой, так как они играют ключевую роль в образовании красных кровяных клеток и могут помочь в профилактике анемии.
СОВЕТ №3
Не игнорируйте симптомы. Если вы заметили такие признаки, как усталость, слабость, бледность кожи или одышку, обязательно проконсультируйтесь с врачом для проведения необходимых исследований и назначения лечения.
СОВЕТ №4
Следуйте рекомендациям врача по лечению. Если вам поставили диагноз гиперхромия или гиперхромная анемия, важно строго соблюдать назначенное лечение и регулярно посещать врача для контроля состояния.